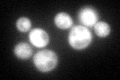
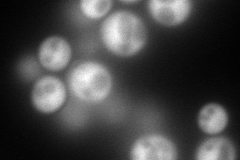
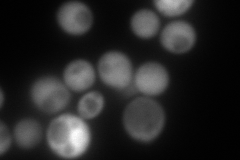
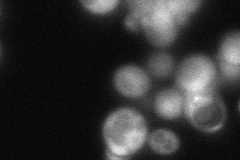

View description
Adenine phosphoribosyltransferase, catalyzes the formation of AMP from adenine and 5-phosphoribosylpyrophosphate; involved in the salvage pathway of purine nucleotide biosynthesis
Localization:
Intensity:
Fold change:
Significance:
-
C’ GFP library in SD
cytosol110.53 -
N' NOP1pr-GFP in SD
cytosol284.162 -
N' TEF2pr-mCherry in SD
cytosol165.362 -
N' NATIVEpr-GFP in SD
cytosol79.178 -
N' TEF2pr-VC and Cyto-VN in SD

#N/A0 -
C’ GFP library in SD+DTT

cytosol62.180.56Yes -
C’ GFP library in SD+H2O2

cytosol97.240.87No -
C’ GFP library in Starvation Media

cytosol43.620.39No -
C’ GFP library on the background of Pup2-DaMP

cytosol -
C’ GFP library on the background of CCT mutant

cytosol89.32060.808051No
